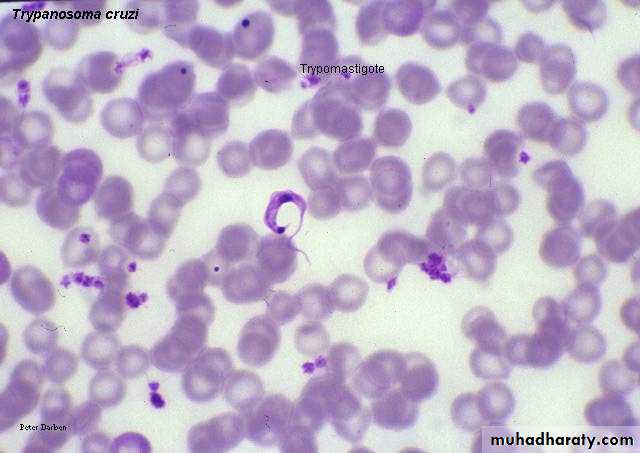

Blood &tissue protozoa
(Haemo-flagellates)Lec:1
د.اكرام الحسو
Blood and tissue Protozoa (Haemo-Flagellates)
• Genus Leishmania• Genus Trypanosoma
Morphological forms of hemoflagellates
1-Amastigote (Leishmania) formRound or oval in shape.
2-5 microns in diameter, have single nucleus with large central karyosome, the kinetoplast (which consists from dot-like blepharoplast and parabasal body beside it) lies at right angle to the nucleus.
This form has no flagellum.
2-Promastigote (leptomonad) form
Elongated (spindle in shape).15-20 microns X 1-2 microns.
Have centrally located nucleus and the kinetoplast situated at the anterior end.
From blepharoplast, single free flagellum projects from the anterior end.
This form has no undulating membrane.
3-Epimastigote form
Elongated form.15-20 microns long and slightly wider than promastigote.
Nucleus near middle, kinetoplast is anterior to the nucleus. From blepharoplast flagellum arises forming the undulating membrane extending half of the body length, and project from the anterior end as a free flagellum.
4-Trypomastigote (Trypanosome) form
Elongated form (15micron X 2-4micron) .Nucleus near middle, kinetoplast is at the posterior end, the flagellum and undulating membrane pass anteriorly along entire body length and free flagellum extends from anterior end.
Genus Leishmania
include 4 major speciesLeishmania donovani
Leishmania tropica
Leishmania Mexicana
Leishmania braziliensis
Leishmania donovani
L. donovani is the cause of kala-azar (visceral leishmaniasis, black fever).life cycle
Sand fly
PathogenesisThe organs of the reticuloendothelial system (liver, spleen and bone marrow) are the most severely affected.
Reduced bone marrow activity with cellular destruction in the spleen.
The striking enlargement of the spleen is due to a combination of proliferating macrophages and sequestered blood cells.
Epidemiology
the Mediterranean areathe Middle East
southern Russia, and parts of China, Africa, India and neighboring countries (Kenya)
Clinical Findings
Intermittent fever, weakness, and weight loss.Massive enlargement of the spleen is characteristic.
Hyperpigmentation of the skin.
As anemia, leukopenia, and thrombocytopenia become more profound, weakness, infection, and gastrointestinal bleeding occur.
Untreated severe disease is nearly always fatal as a result of secondary infection.
Post Kala-azar dermal leishmaniasis (PKDL) (Dermal-Leishmaniod)
It is a dermatotropic form of leishmaniasis,it is an immune reaction due to incomplete treatment, it is found in areas where L. donovani is the causative agent of VL and develops after 2-10 years from VL.Three clinical type of PKDL are encountered:
1- Depigmented macules.
2- Erythmatous pathches.
3- Nodular lesions.
Diagnosis of kala-azar
1- Microscopic detection of amastigotes (LD bodies: Leishman-Donovan) in Giemsa stained smear of bone marrow, spleen and lymph node or liver.
2- Cultivation of aspirates in specific culture medium as NNN (Novy-MacNeal-Nicolle) medium → promastigotes seen.
3- Serological method (detection of specific anti-leishmanial antibodies):
· IFAT (indirect immunofluorescent antibody test)· DAT (Direct agglutination test)
· ELISA (enzyme linked immunosorbent assay)
4- Molecular method (PCR polymerase chain reaction) the most sensitive and specific diagnostic method.
Treatment:
bed rest, high protein &vitamen diet,antibiotics in secondary bacterial infections, blood transfusion in case of anemia.Sodium stibogluconate(Petnostam), Amphotericin B.
Prevention
Prevention involves protection from sandfly bites (use of netting, protective clothing, and insect repellents) and insecticide spraying.Leishmania tropica , Leishmania mexicana & Leishmania braziliensis
Disease
L. tropica and L. mexicana both cause cutaneous leishmaniasis.
L. braziliensis causes mucocutaneous leishmaniasis) Espundia(.
Pathogenesis
The lesions are confined to the skin in cutaneous leishmaniasis and to the mucous membranes, cartilage, and skin in mucocutaneous leishmaniasis)Espundia(.
Epidemiology
Old World cutaneous leishmaniasis (Oriental sore, Baghdad boil, Delhi boil), caused by L. tropica, is endemic in the Middle East (Iraq, Syria, Palestine, Iran, and Jordan), Africa, and India.New World cutaneous leishmaniasis (bay sore), caused by L. mexicana, is found in Central and South America.
Mucocutaneous leishmaniasis (espundia), caused by L. braziliensis, occurs mostly in Brazil and Central America.
Clinical Findings
A: cutaneous leishmaniasisThe initial lesion is a red papule at the bite site, usually on an exposed extremity. This enlarges slowly to form multiple satellite nodules that coalesce and ulcerate.
There is usually a single lesion that heals spontaneously in patients with a competent immune system.
In certain individuals, if cell-mediated immunity does not develop, the lesions can spread to involve large areas of skin.
B. Mucocutaneous leishmaniasis) Espundia)
begins with a papule at the bite site, but then metastatic lesions form, usually at the mucocutaneous junction of the nose and mouth. Disfiguring granulomatous, ulcerating lesions destroy nasal cartilage but not adjacent bone. These lesions heal slowly.Death can occur from secondary infection.
Diagnosis
1- clinical grounds2- Microscopic detection of amastigotes (L.D. bodies)
3- Culture: on NNN media will demonstrate promastigote forms.
4- Animal inoculation: aspirate or biopsy material may be inoculated subsequently into the nose of a hamster and the animal watched for nasal inflammation.5- Leishmanin skin test (Montenegro test): involves the forearm intradermal injection of 0.1 ml suspension of killed promasitigote, this test is used to measure delayed hypersensitivity. Positive result is indicated by an induration of 5mm or more in 48-72 hours. In cutaneous leishmaniasis this test is positive.
6- Immunological test (serology): has limited role in diagnosis because patient shows no detectable level of circulating antibodies.
Treatment
1- Sodium stibogluconate (Pentostam)2- Amphotericine B
Prevention
Prevention involves protection from sandfly bites by using netting, window screens, protective clothing, and insect repellents.
Genus Trypanosoma
includes three major pathogens:Trypanosoma cruzi
Trypanosoma gambiense
Trypanosoma Rhodesiense
Trypanosoma cruzi
Disease: American trypanosomiasis, Chagas’ diseaseLife cycle
Modes of transmissionBite of reduviid bug (commonest mode).
Blood transfusion in endemic areas.
Congenital transmission.
Reduviid bug
Epidemiology
in rural Central and South America (temperature&humidity).Pathogenesis
The amastigotes can cause inflammation, consisting mainly of mononuclear cells.
Cardiac muscle is the most frequently and severely affected tissue. In addition, neuronal damage leads to cardiac arrhythmias and loss of tone in the colon (megacolon) and esophagus (megaesophagus).
During the acute phase, there are both trypomastigotes in the blood and amastigotes intracellularly in the tissues. In the chronic phase, the organism persists in the amastigote form.
Clinical Findings
The acute phase of Chagas’ disease : consists of facial edema and a nodule (chagoma) near the bite site, coupled with fever, lymphadenopathy, and hepatosplenomegaly. A bite around the eye can result in unilateral palpebral swelling & conjuctuvitis ( Romana’s sign). The acute phase resolves in about 2 months.Most individuals then remain asymptomatic, but some progress to the chronic form with myocarditis and megacolon.
Diagnosis
1- Microscopic detection of trypomastigotes in peripheral blood:the parasites are typically C or U shaped with projecting kinetoplast.
2- Culture: on NNN medium.
3- Biopsy examination: lymph node is examined for amastigotes.4- Serological diagnosis: IFAT , RIA (radioimmunoassay) , ELISA.
5- PCR (polymerase chain reaction).
Treatment
nitrofuranBenznidazole
Prevention
Prevention involves protection from the reduviid bite, improved housing, and insect control.
No prophylactic drug or vaccine is available.
Blood for transfusion is tested for the presence of antibodies to T. cruzi. Blood containing antibodies should not be used.
Trypanosoma brucie
• T. gambiense• T. rhodesiense
Disease: African Trypanosomiasis, Sleeping sickness.
Life cycle of T. bruciePathogenesis
The trypomastigotes spread from the skin through the blood to the lymph nodes and the brain. The typical somnolence (sleeping sickness) progresses to coma as a result of a demyelinating encephalitis.
Epidemiology
sub-Saharan Africa (temperature&humidity)T. gambiense is the species that causes the disease in west Africa
T. rhodesiense is found in east Africa. Both species are found in central Africa.
Clinical Findings
sleeping sickness
T. gambiense–induced disease runs a low-grade chronic course over a few years
T. rhodesiense causes a more acute, rapidly progressive disease that, if untreated, is usually fatal within several months.
The initial lesion is an indurated skin ulcer (trypanosomal chancre) at the site of the fly bite.
intermittent weekly fever and lymphadenopathy
Enlargement of the posterior cervical lymph nodes (Winterbottom’s sign)
encephalitis is characterized initially by headache, insomnia, and mood changes, followed by muscle tremors, slurred speech, and apathy that progress to somnolence and coma.
Diagnosis of African trypanosomiasis
1-Microscopic detection of trypomastigotes in trypanosomal chancre,Peripheral blood,Bone marrow,Lymph node aspiration or CSF.2-Serological diagnosis:
-IFAT (indirect fluorescent antibody test).-IHT (indirect haemoagglutination test).
-ELISA.
3-Serum and spinal fluid IgM measurement: are of diagnostic value, because in many cases the total serum IgM exceeds eight (8) times the normal amount.
4-Animal inoculation.
Treatment
SuraminPentamidine
melarsoprol.
Prevention
protection against the fly bite, using netting and protective clothing. using insecticides are helpful measures. No vaccine is available.Thank you